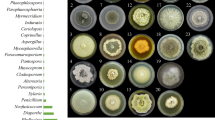

Abstract
This paper discusses the importance of culture collections in plant pathology and reviews the methods currently available to store cultures. The preservation and maintenance of plant pathogenic fungi in a viable yet stable state for long periods has always been important, because isolates of these fungi can serve as standards for identification of quarantine taxa. Such isolates are also important for testing disease resistance and for plant breeding programs. The increasing use of molecular sequences analysis in the systematics of plant pathogenic fungi has meant that maintaining fungi in culture collections has become essential. Herein we discuss trends in the identification of plant and post-harvest pathogens, using Aspergillus, Colletotrichum, Phyllosticta and Mycosphaerella and its anamorphs as examples. Herbarium specimens, although still a requirement of the Botanical Code when describing new species are, perhaps, less important in providing useful information when defining a pathogenic species. Many pathogen groups consist of complexes of species and morphology alone can no longer distinguish among species. However, ex-type living cultures are essential for identification and future species comparisons that incorporate the use of molecular techniques. As such, ex-type cultures of any new species of pathogen, or when new diseases are reported or studies involving pathogenic strains are published, cultures of the taxa studied should be deposited in widely available culture collections, preferably in at least three members of World Federation for Culture Collections. Methods for the storage of fungal cultures such as water preservation, freezing, mineral oil overlay, freeze drying and lyophilization are reviewed in this paper. The main objective of culture preservation is to maintain the vigor and genetic characteristics of a pure culture. Therefore, safe long-term preservation methods are required to ensure fungal survival and retention of any valuable characteristics. To minimize the risk of any morphological, physiological, or genetic changes, several different preservation conditions should be used whenever possible. The present review also describes a complete preservation methodology that can be used for plant pathogenic fungi.
Similar content being viewed by others
Avoid common mistakes on your manuscript.
Introduction
Fungi are some of the most important organisms in the world. They play vital roles in ecosystem functioning (Stephenson 2010) and also have a considerable influence on humans and human-related activities (Pointing and Hyde 2001). Plant pathogens are among the most important of all fungi, since they have profound negative influences in many different types of ecosystems. For example, some plant pathogens cause huge losses in crop and tree production and spoilage of commodities in post-harvest storage (Agrios 2004); others, such as Phytophthora cinnamomi in Australia, may impact negatively on natural ecosystems (Cahill et al. 2008). Culture collections are libraries containing examples of the genotypic and phenotypic diversity of plant pathogens. Thus, they represent irreplaceable and invaluable resources that are essential for advancing future research in plant pathology and related disciplines. They also provide a vital source of information from which to develop and assess control and regulatory methods to be used against threats from new and re-emerging pathogens (Kang et al. 2006).
Historically, herbaria have been depositories of fungal diversity and have been used to store voucher specimens and type material of particular species for future comparisons (Hawksworth 1974). However, since plant pathogens are often complexes of species (O’Donnell et al. 2004; van Niekerk et al. 2004) and since each taxonomic entity within a given complex cannot be identified solely on the basis of morphology, herbarium material has less significance than previously. Living material is essential for distinguishing species and a major portion of the materials in most herbaria is old and has been dead so long that DNA cannot easily be extracted and sequenced. As such, fungal culture collections are absolutely essential to preserve fungi for future use. For example, long-term preservation of fungal cultures in a viable and stable state is exceedingly important and essential for future studies relating to pathogen identification, disease control, quarantine and breeding resistant plants.
In this paper we review the advances that have taken place in the naming of plant pathogens and the associated need for living reference collections containing ex-types (i.e., culture collections). Culture collections have become the ‘new herbaria’ for plant pathogens. We also review the methods available to preserve plant pathogens as living cultures.
Herbaria and culture collections: historical aspects
Mycologists have been collecting fungi for scientific purposes for more than 300 years, and they have deposited dried specimens of these fungi as exsiccata or in government or private herbaria. In 1955 the Botanical Code stipulated that for any species described as new to science, type material should be deposited in a recognized herbarium and that the place of deposition should be designated. If the place of deposition (usually a herbarium) was not named in the publication, the name was deemed invalid.
Culture collections, which are a more recent development, are brought together under the World Federation for Culture Collections (WFCC). The WFCC is concerned with the collection, authentication, maintenance and distribution of cultures of microorganisms and cultured cells. Its aim is to promote and support the establishment of culture collections and related services, to provide liaison and set up an information network among the collections and their users, to organise workshops and conferences, publications and newsletters and work to ensure the long term perpetuation of important collections [http://www.wfcc.nig.ac.jp/aboutwfcc.html]. Culture collections evolved as an attempt to preserve fungi in a viable state for future studies in plant pathology, biosecurity, industry and biodiversity. The advantage of culture collections over herbaria is that they contain living material. Users are increasingly demanding access to taxonomic information through identifications based on DNA sequences, rather than morphology of fruiting bodies. However, with continuing subculture and storage, the characteristic morphology and unique physiological attributes of plant pathogenic fungi may change or be lost over time. Attempts to stop or reduce such biological changes have been undertaken by scientists as long as fungi have been cultured and stored. The first report on the preservation of fungi in distilled water was by Castellani (1939). Many fungi, including Alternaria sp., Rhodotorula sp., Penicillium notatum, Aspergillus niger and Candida albicans, were maintained in a viable condition for many months. The protocol described by Castellani, in addition to being easy and economically feasible for small laboratories, yields satisfactory results for the maintenance of most species of fungi (Onions 1983; Hartung de Capriles et al. 1989; Rodrigues et al. 1992). Viability is dependant upon the particular organism involved, thus improved methods to retain both viability and morphological stability over long periods was needed (Borman et al. 2006).
Advances in understanding the classification of plant pathogens
The identification of species in genera of plant pathogenic fungi has always been, and still remains, complicated. Until recently species were named mostly on the basis of morphological characters, but there are numerous instances in which it is has been shown that a particular species is in fact a complex of many species. Some notable examples include Cercospora apii, a complex of numerous cercosporioid taxa (Crous and Braun 2003); Fusarium oxysporum, a complex of more than 50 taxa (Kvas et al. 2009); and Colletotrichum gloeosporioides, which is presently being studied and is likely to consist of numerous species (Phoulivong et al. 2010). Recent advances in the naming of species in such genera as Aspergillus, Colletotrichum, Phyllosticta and Mycosphaerella and its anamorphs are discussed in more detail below.
Aspergillus
The systematic treatment of Aspergillus is currently based on morphology, along with some molecular and extrolite data (Hong et al. 2005). It has long been known that morphological species concepts in the genus were too broad and often consisted of several species or even groups containing many evolutionarily divergent species (Geiser 2004; Pringle et al. 2005; Balajee et al. 2005). Molecular data are currently supplying the primary characters used to establish the taxonomic framework of Aspergillus (Geiser et al. 2007). The advantage of using molecular data is that they provide a remarkably greater number of variable characters that do not change according to environmental conditions. These characters are more objective and consistent when compared to morphological characters; they also allow for convenient international communication and information sharing. In addition, well-developed bioinformatics tools cause the information to be less controversial when different scientists analyze the same pool of data. Dried herbarium samples, as compared to living type cultures, do not provide satisfactory materials for DNA extraction and subsequent molecular study. Therefore, dried herbarium samples are being given less and less attention as researchers carry out studies on Aspergillus.
Extrolites and physiological features, although previously applied less often, have now become one important approach for studying species of Aspergillus. A combination of molecular and extrolite data and/or physiological features can result in a natural classification and allow scientists to make a correct diagnosis of species of Aspergillus (Frisvad et al. 2007). Secondary metabolites, which ideally could be used as tool for diagnosis, are the molecules used most often for species reorganization, as species produce unique profiles and some of these components are unique to specific species (Nielsen et al. 2004; Larsen et al. 2005). Growth and enzyme profiles have been satisfactorily applied to the taxonomy of the black-spored aspergilli (Murakami et al. 1979; de Vries et al. 2005) and the possible use of this approach for all groups of Aspergillus has been suggested (Frisvad et al. 2007). Again, without living cultures, this approach would not be possible.
Although a herbarium specimen can serve as a long-lasting morphological template for diagnosing species of Aspergillus, the systematic treatment of Aspergillus is no longer morphology-based. Herbarium specimens are not reproducible and are subject to loss, destruction, or depletion. Aspergillus serves as a good example to illustrate the importance of living cultures for systematic and other studies. Fortunately, most of the known species have living ex-type cultures.
Colletotrichum
Colletotrichum (teleomorph known as Glomerella) is the causal agent of anthracnose and other diseases of the leaves, stems and fruits of numerous species of vascular plants, including some important crops (Agrios 2004). The systematics and species concepts in Colletotrichum are very confusing. Morphologically indistinguishable species have been classified in species complexes that actually contained phylogenetically and biologically isolated species. For example, species identified as C. gloeosporioides have been recorded from nearly 2000 different plant species (as per the USDA fungi-plant database), but many of these fungi are likely to represent distinct taxonomic entities.
Recently, a special issue dedicated to studies of the genus Colletotrichum was published in Fungal Diversity (vol. 39, Dec 2009). This volume served as a fresh starting point for studies of Colletotrichum, with previous work reviewed, currently used names listed, approaches for species recognization proposed and standard methodologies suggested. Morphology-based species recognization is rapidly becoming superseded by a molecular-based polyphasic approach. Living ex-type cultures are essential for phylogenetic reconstruction, and comparative studies of growth rate, carbon source utilization and secondary metabolite profiles. Living cultures can also be used to produce morphological features such as haustoria; features which may not be present on the original material.
There are 46 species of Colletotrichum that are currently provided with ex-type cultures (Hyde et al. 2009). The existence of a living culture has become a precondition for establishing the systematic placement of a particular species and its phylogenetic relationships in Colletotrichum (Cai et al. 2009). Epitypification (with designation of ex-epitype living cultures) of some important species such as C. gloeosporioides (Cannon et al. 2008) has made it possible for the first time to fully resolve this complex, which apparently contains numerous species (Phoulivong et al. 2010). Therefore, previous studies that involved C. gloeosporioides should be reconsidered to establish if the identification of the fungus in question was correct. Such studies may give erroneous data on the distribution of pathogens of quarantine concern. A recent study isolating fruit rot causal agents from Asian fruits has shown that the so-called ubiquitous tropical anthracnose causal agents, C. gloeosporioides and C. acutatum, are most likely other species (Phoulivong et al. 2010). Recent neotypification of C. falcatum, the causal agent of the red rot of sugarcane, also revealed that most sequences deposited in GenBank under the name “Colletotrichum falcatum” are not conspecific with the neotype. Living ex-type cultures now available from an increasing number of taxa of Colletotrichum have paved the way for a stable, consistent, reliable and useful species classification.
The question could be asked as to whether or not we should continue to use both Colletotrichum and Glomerella when providing a modern treatment for the anthracnose pathogens. The Botanical Code allows for different states of the same organism to be assigned to different genera, although with molecular data now becoming available to link the asexual and sexual states, this no longer seems to make sense. If the deposition of living states of types was a requirement of the Botanical Code, and thus these types were available in culture collections, it would become easier to link the sexual state of species in the future. At some point, it might even be possible to change the Code and to use only one name (the asexual or sexual name) for each species; this name may be the most well known name, rather than by default the teleomorph name.
Phyllosticta
Guignardia and its asexual state Phyllosticta are genera desperately in need of modern revision. Guignardia has not been monographed and more than 335 species epithets have been listed under this genus. van der Aa (1973) gave an account of 46 species of Phyllosticta, which he accepted in the genus. Later, van der Aa and Vanev (2002) listed all names proposed in Phyllosticta, suggesting redisposition of many of them. Recent phylogenetic study has revealed the difficulty in identifying species of Guignardia and Phyllosticta as there are few morphological characters to differentiate among species, while few living types are available in culture collections for sequencing. In many endophyte studies, isolated strains of Guignardia have been assigned to Guignardia mangiferae (G. endophyllicola) (Okane et al. 2003). The type of this taxon, which was described from mango in India (Roy 1968), apparently no longer exists (Wulanderi, pers. comm.) and ascospores in the protologue are typical of numerous species in Giugnardia (e.g. G. musae F. Stephens, G. cocoes [Petch] K.D. Hyde) which might be more appropriate earlier names. Therefore, even though numerous sequences have been deposited in GenBank under this putative species name, the name is inappropriate. As such, it is important to find earlier names with this typical ascospore type and epitypify new collections from the same host. Once the epitype can be sequenced, it can be established whether or not species with the same ascospore type are separate species in a species complex or represent a single taxonomic entity and genes can be found that differentiate species.
In a similar way, the type of Guignardia citricarpa, which causes citrus black spot, an important disease of orange, is apparently lost. Wulanderi et al. (2009) described Phyllosticta citriasiana, which causes citrus tan spot in the Asian region, and differentiated it from G. citricarpa on the basis of morphology and molecular data. Wulanderi et al. (2009) used what they considered to be authentic strains of G. citricarpa for comparison with their new species. However, Wulanderi et al. (2009) could not compare their new species with the type of G. citricarpa. Even if a type had been available, it would have been more than 60 years old and unlikely to yield DNA for sequencing and comparison. An epitype for G. citricarpa needs to be found on orange in Australia. This is a good example of an instance in which an epitype needs to be found for an important pathogen of quarantine significance. Although it is a requirement of the Botanical Code (McNeill et al. 2006) to deposit a herbarium specimen of the epitype in a designated herbarium, it is probably important to deposit living cultures of the epitype in culture collections for future work with the living organism.
Our understanding of species within the genera Guignarida and Phyllosticta lags far behind the situation for Aspergillus and Colletotrichum, yet without living cultures it will be impossible to advance beyond the present inadequate morphological-based system, which can only group taxa into species complexes. Once again the need for extype cultures in culture collections seems apparent.
Mycosphaerella and its anamorphs
Mycosphaerella and its anamorphs have long been poorly understood. The genus is polyphyletic and has anamorphs distributed in more than 30 genera (Crous and Braun 2003; Crous et al. 2007; Crous 2009). The characters that separate sexual stages, in particular, are few in number and in the past many species were placed in Mycosphaerella sensu stricto, but recent work has shown that members can be placed into at least five families (Crous et al. 2007; Crous 2009). The anamorphs have been placed in several anamorphic genera including Cercospora sensu stricto and Cladosporium sensu stricto. Both of these genera have undergone reorganisation, at first based on morphological features (e.g., Deighton 1974, 1976; Crous and Braun 2003) but, more recently, by a combination of morphological and molecular data (e.g., Crous et al. 2001, 2006). For future studies there is a basic need for living cultures that represent all of these genera, and ultimately for cultures of all species.
A recent paper on the sooty blotch disease of apple describe two genera that closely resemble Pseudocercosporella (Frank et al. 2010). The type of the genus is P. ipomeae (P. bakeri) and it has no living culture. Therefore, an effort was made to find a new collection to designate as an epitype, which they sequenced. By doing this they were able to describe the causal agent of sooty blotch disease on apple as a new species in a new genus, illustrating the importance of having living cultures of taxa available. The designated epitype material (a requirement) will become old with time and its usefulness will decrease. Therefore, the living epitype was deposited in CBS (not a requirement) and is available for future studies of any kind.
Requirement to deposit living cultures of plant pathogens
In each of the genera mentioned above, species names are based on sequence data as well as morphological characters. However, the former has generally taken precedence in differentiating taxa, especially those in species complexes. Some type strains have been sequenced and the resulting sequence data deposited in GenBank; as such, GenBank serves as a repository of very important data. However, Cai et al. (2009) found that 86% of ITS sequences named as Colletotrichum gloeosporioides in GenBank are wrongly applied. It is not possible to go back and check the identities of many of these fungi, since they do not have associated herbarium material and more importantly, many do not have preserved living cultures. Even if herbaria material was available, it might be of little use, as morphological characters may not be useful for distinguishing species. Therefore, to be truly useful, GenBank accessions should have associated living material as isolates in recognized culture collections as well as being represented by dried herbarium material.
At this time, ITS, SSU, LSU and a few other gene regions are sequenced routinely in fungal pathogens, and ITS has been recommended as the barcoding gene. However, we cannot predict which gene will be most informative in the future, and the popular gene regions of today may be replaced by genes with better resolution in the future. When this happens, it is essential that living isolates are available for future studies. This may include not only genes, but other areas of science, such as proteomics, which have not yet proven to be useful in classification studies.
In addition to the traditional reasons, such as determining resistance against fungicides and use in plant breeding programs, the example described above highlights the need for isolates of plant pathogens to be deposited in culture collections. Our recommendation is that scientific journals require cultures from all published studies to be deposited in international culture collections and that the mycological communities should consider making the deposition of isolates a strong recommendation of the Botanical Code when describing new species (at least those of cultivatble microfungi). Unfortunately, this cannot be a universal requirement of the Code, since not all fungi will grow in artificial culture.
Recommendations
Based on what has been discussed thus far, we suggest that the following recommendations should be considered.
-
1.
When sequence data obtained from living isolates of fungi are deposited in GenBank, the entry should be accompanied by details indicating that a culture of the fungus in question has been deposited in a minimum of three recognized international culture collections.
-
2.
When a new taxon is introduced, and a living isolate is available, publication details should provide information indicating that the cultures are deposited in a minimum of three recognized international culture collections.
Culture collections, the new herbaria
Like Latin descriptions, which are a requirement of the Botanical Code, but in our opinion should be considered outdated and unnecessary, the sole requirement for deposition of dried herbarium material in preference to living cultures is also questionable. Where possible, both living cultures (where possible) and dried herbarium specimens should be deposited for every fungus described as new to science.
The need for herbaria
The importance of dried herbarium specimens versus living cultures has been questioned, but it also could be argued that both may be equally important. In a recent study, we revived several cultures of Stemphylium from a culture collection. In nearly every case, the cultured isolates had lost their vigour for growth and, even more importantly, they had lost their ability to produce conidia. Therefore, although the living material was available for sequencing, we had no idea of the morphological characters of the collections. Fortunately, in most cases, the material from which the isolates were taken had been deposited as herbarium material. There is also the ability to produce dried cultures of fungi and to deposit these in a herbarium. Such dried cultures will likely show colony characteristics, provide an indication of growth rate and, for many fungi, wild-type spores and fruit bodies will be present.
Culture collections
Many methods have been used for the preservation of living fungi. These include preservation on agar slants with periodic transfer, in sterile water (McGinnis et al. 1974), silica gel (Perkinsd 1962), soil (Bakerspiegel 1953), on oil covered slants (Buell and Weston 1947), cryopreservation at low temperatures (−80°C), storage in liquid nitrogen vapour (−130–−180°C) (Carmichael 1962; Elliott 1976; Stalpers et al. 1987; Chandler 1994), and as freeze-dried cultures (lyophilization) (Schipper and Holtman 1976). Several references for culture preservation can be sourced from http://ukncc.co.uk/html/Information/Collection%20management.htm. The selection of a particular technique of cultural preservation depends upon the anticipated use of the organism as well as the time, facilities and resources available (Manoharachary et al. 2005). No single technique has been applied successfully to all fungi, although storage in or above liquid nitrogen is now well developed for many fungal strains. Managers of culture collections must select a suitable method for each fungus, perhaps using a second method as a back-up, but certainly including multiple cultures for each strain. Fungal preservation requires care and is not always easy. Moreover, novel techniques are sometimes necessary to maintain viable fungal cultures for longer periods of time.
Preserving isolates of relevant pathogens from past disease epidemics is equivalent to medical researchers keeping historical isolates of pathogens from previous epidemics or outbreaks, or to archiving the key documents needed for understanding an important historical event (Kang et al. 2006). The second part of this review provides an account of various preservation procedures relating to the growth and maintenance of plant pathogenic fungi.
Methodology and advantages
Preservation of fungi in water
The least expensive and most low-maintenance method for preservation of fungal cultures is water storage, in which the cultures are immersed in distilled water (Boesewinkel 1976; Ellis 1979). There are two simple techniques that can be used for preparing cultures for water preservation.
-
1.
Several disks, cut from fungal cultures grown on an appropriate medium, are transferred to sterile, small screw-cap vials filled with several milliliters of sterilized water. Prepared cultures must be capped and stored either at room temperature or kept cooled.
-
2.
Agar slants previously prepared in screw-capped tubes are inoculated with fungal cultures and then incubated for 2 wk at an appropriate temperature. Slanted cultures with suitable growth are covered with 6–7 ml of sterile distilled water and gently agitated to release the fungal spores and hyphae. The fungal suspension obtained in this manner is aseptically transfered to sterile glass vials, which are then tightly capped to prevent water evaporation, labeled and then stored at 4°C (McGinnis et al. 1974).
The water preservation method has been used successfully to maintain Aspergillus fumigatus, A. niger, Aspergillus sp., Cladosporium bantianum, C. carrionii, Fusarium sp., Mucor sp., Penicillium nonatum, Penicillium sp., and Rhizopus sp., for up to one year (Diogo et al. 2005). Burdsall and Dorworth (1994) used this method to maintain 151 species of wood-decaying members of the Basidiomycotina for varying periods up to 7 years. They noted that water storage is a quick, easy, and inexpensive method that may maintain genetic stability. In addition, oomycetes, ascomycetes and hyphomycetes can be maintained by this method. High recovery rates were reported for cultures of Phytophthora clandestina stored in sterile deionised water on millet seeds,without loss of pathogenicity (Simpfendorfer et al. 1996). Isolates of Gaeumannomyces graminis stored as agar plugs in sterile water at ambient temperature have survived more than 20 years (Hornby et al. 1998). The virulence of isolates of Gaeumannomyces graminis var. graminis against wheat plants was maintained and did not seem affected even after 10 years (Elliott 2005). Storage of species of Botryosphaeria from grapevine as mycelium plugs in sterile water at 4°C has been reported as a better method for maintaining viability and preservation of growth rates compared with mineral oil (Baskarathevan et al. 2009).
Mineral oil preservation
The second low cost and simple preservation method for fungal cultures involves the use of mineral oil and was first employed by Sherf (1943). In this method, suitable fungal growth is transferred to a slanted screw cap vial containing PDA or other suitable medium and incubated for 2 wk at an appropriate temperature. Vials with clean normal growth are then covered with a small amount of sterile mineral oil. Vials may also be sealed with Parafilm prior to storage (Elliott 2005). Oil prevents dehydration of the media over a long period of storage. Effectiveness of this method has been proven during the course of many investigations involving different groups of fungi (Buell and Weston 1947; Pumpianskaya 1964; Perrin 1979; Bunny 1981).
This simple method has been used successfully to preserve a number of different fungi, including Colletotrichum gloeosporioides, C. gossypii, C. nigrum, Coniothyrium conicola, Diplodia cajani, Phomopsis sp., Pyrenochaeta romeroi and Septoria lycopersici (Borba and Rodrigues 2000). It is an appropriate way to preserve oomycetes, which are difficult to keep by other methods. In addition, it was used for the fungal plant pathogen Gaeumannomyces graminis var. graminis by Bunny (1981), who stated that strains stored on oil covered slants maintained their virulence on wheat plants better than those kept on ordinary agar slants. Preservation on agar slopes under oil also was demonstrated to be effective for ectomycorrhizal basidiomycetes (Heinonen and Holopainen 1991).
Silica gel preservation
Storage in silica gel is inexpensive and simple and has been demonstrated to be trustworthy for maintaining genetic markers. The silica gel method as developed by Perkinsd (1962) can be used to preserve viable cultures for 4–5 years, depending on the culture medium and fungal strain used. Since the silica gel can prevent all fungal growth and metabolism, the risk of any morphological, physiological, and genetic changes may be minimized.
For silica gel preservation, fungal cultures are grown on an appropriate medium for 3–5 days to achieve a suitable growth. Screw-cap tubes are then filled with 6- to 22-mesh sterilized silica gel (180°C for 90 min). The silica gel is then chilled to about 4°C and placed in an ice-water bath. Spores are suspended in a 10% (v: v) solution (previously cooled to 4°C) of dry powdered skimmed milk in distilled water. The spore suspension is added to the silica gel and left for 30 min in the ice bath. Tubes are kept for 1–2 wk at room temperature and viability is assessed on agar plates. If the cultures are viable, the caps on the tubes are tightened, and the tubes are stored in a tightly sealed container at 4°C.
Since Perkins (1962) described the technique, cultures of Aspergillus nidulans (Barrett et al. 1965), Rhodotorula sp. (Reinharddt 1966), Claviceps paspali (Mizrahi and Miller 1968), Ustilago rnaydis (Puhallaj 1968), Saccharomyces cerevisiae (Grivell and Jackson 1969), A. parasiticus (Mayner et al. 1971), Endothia parasitica (Puhallaj and Anagnostaksi 1971), Candida spp. (Parinao et al. 1972), Fusarium oxysporum and Verticillium spp. (Rogers 1972) have been preserved on silica gel. In addition, the silica gel preservation method also has been used successfully to preserve several other fungi (i.e., Aspergillus niger, Fusarium oxysporum, Gliocladium sp., Mucor hiemalis, Penicillium sp., Saccharomyces cerevisiae, Sordaria fimicola, Thamnidium elegans and Verticillium spp.) as reported by Trollope (1975) and 17 species of Fusarium as indicated by Windels et al. (1988, 1993). In addition, silica gel has also been used to preserve the viability of spores of rust fungi, which cannot be grown on agar. The disadvantages of the silica gel preservation method is that some fungi may loose the ability to sporulate, and the time of storage is quite short (between 2 and 4 years) (Onions 1983; Smith 1993).
Preservation in soil or sand
Since described by Atkinson (1954), soil has been used to preserve fungal cultures for extended periods. Some of the phytopathogenic fungi, particularly those belonging to soil-borne groups, have been preserved by this method. In this method, soil with 20% water content, or sand, is placed in 60 ml glass bottles and sterilized by autoclaving at 121°C for 25 min. One milliliter of a fungal spore suspension, prepared by adding an appropriate volume of sterilized water to a 1 week-old culture, is added to each bottle. After incubation for 2–14 days at room temperature, bottles with good fungal growth are stored at 4°C. This method was used successfully for the preservation of Septoria by Shearer et al. (1974) and Borba and Rodrigues (2000), Pseudocercosporella by Reinecke and Fokkema (1979), Rhizoctonia by Sneh et al. (1991) and Fusarium spp. by Windels et al. (1993).
Use of organic materials
Several techniques have been developed over the years for preservation of pathogenic or other host-specific fungi, particularly those that need specific organic substrates. Cereal grains, straw, filter paper, wood chips and insects are some of the organic substrates that have been used. A number of different cereal grains (e.g., barley, millet, oats, rye, sorghum, wheat) can be used for the preservation of phytopathonenic fungi. In this method cereal seeds are prepared by soaking them overnight in water containing chloramphenicol (50 ng/ml). The water is removed and the grains are placed in screw-cap vials and autoclaved for 1 h at 121°C over 2 consecutive days. Vials are inoculated with actively growing cultures and incubated at 23–27°C for 7–10 days. Cultures are then dried thoroughly in a desiccation chamber. The caps on the vials are tightened and wrapped with Parafilm, and the vials stored at −25°C (Sneh et al. 1991). In our laboratory, we have used different preparation methods in which a weighed amount of cereal grains was put into a 50 ml conical flask, an equal volume (w-v) of distilled water added and the flasks were autoclaved at 121°C for 30 min. Flasks were inoculated with a particular fungal isolate and incubated at a temperature suitable for further growth. Small amounts of the colonized seeds were aseptically transferred to sterile 2 ml eppendorf tubes, labeled and stored immediately at −80°C.
Singleton et al. (1992) mentioned that grains of oats, barley, wheat, rye, millet, and sorghum could be used to preserve species of phytopathogenic fungal from such genera as Leptosphaeria, Magnaporthe, Rhizoctonia and Sclerotinia for periods up to 10 years. This method also can be used for preserving several known plant pathogenic fungi such as Cephalosporium, Fusarium and Sclerotium. Cultures of Phytophthora clandestina were successfully stored in sterile deionised water on millet seeds, and they maintained high recovery rates after 10 months without any loss of their pathogenicity (Simpfendorfer et al. 1996).
Wood chips and toothpicks have been used successfully for long-term preservation of some wood-infecting fungi for up to 10 years (Nelson and Fay 1985; Delatour 1991). Small wood pieces or toothpicks are sterilized at 121°C for 20 min in plugged test tubes. Tubes are inoculated by placing 4 mm disks cut from the margins of fresh plated fungal cultures and incubated until an even fungal colonization of the wood is observed. The colonized wood is transferred to sterile test tubes containing a small amount of 2% malt agar, plugged with cotton and incubated for about 1 week, after which, the cotton plugs are replaced with sterile Parafilm and the tubes are then stored at 4°C.
Some plant pathogenic fungi can be stored and maintained on pieces of substrate from their host plant tissues. Plant root infecting fungi such as Pyrenochaeta and Thielaviopsis can be maintained in this way (Singleton et al. 1992). On the other hand, some fungi such as Neozygites fresenii cannot be cultured in vitro, although it can be maintained successfully on frozen, infected aphid mummies (Steinkraus et al. 1993).
Preservation by freezing
Fungal cultures can be kept frozen for many years at −20 to −95°C to maintain viability. There are two procedures used for preserving fungal cultures by freezing. First, slanted cultures can be placed in the freezer immediately after reaching suitable growth (Carmichael 1962). Second, disks cut from vigorously growing fungal cultures can be aseptically transfered to cryovial tubes containing 15% sterilized glycerol solution as a cryoprotectant (Ito and Yokoyama 1983). In general, fungi growing on organic substrates, such as cereal grains, plant parts, agar strips, and toothpicks, can be kept frozen. Several types of phytopathogenic fungi have been maintained by deep freezing for long periods of time. For example, Alternaria alternata, Bipolaris spicifera, Curvularia sp. and Penicillium sp. were maintained on PDA at −70°C up to 13 years (Pasarell and McGinnis 1992) and strawberry pathogenic fungi Colletotrichum fragariae, C. gloeospoioides, C. acutatum and Phomopsis abscurans were maintained in viable conditions up to 21 months without any morphological changes when preserved at −95°C (Legard and Chandler 2000). Cultures of Gaeumannomyces graminis var. graminis were preserved at −75°C (Elliott 2005). Preservation at −20°C was used to store several soil-borne plant pathogenic fungi—Fusarium oxysporum f. sp. lycopersici, Macrophomina phaseolina, Rhizoctonia solani, Sclerotium rolfsii, Sclerotinia sclerotiorum, and Verticillium dahliae (Bueno et al. 2006). Urediniospores of the rust fungus Puccinia psidii were successfully preserved by deep freezing at −80°C (Salustiano et al. 2008). Unfortunately, freezers that can store cultures at −80°C are expensive to purchase, and rely on a continuous supply of electricity, or on a gas-run back-up system.
Preservation in liquid nitrogen (Cryopreservation)
Cryopreservation is considered as the best method for the long-term storage of fungal cultures due to the stability of secondary metabolite production and minimal genetic variations, although certain fungi have exhibited significant degrees of polymorphism after recovery (Ryan et al. 2001; Borman et al. 2006). Cryopreservation is costly but particularly suitable for storage of valuable stock cultures, such as types and patented isolates (Onions 1983). There are various factors that affect the revival success of cyropreserved fungi, such as the cryoprotectant used, the cooling rate, the storage temperature and the thawing rate (Smith 1993). Storage of fungal cultures in liquid nitrogen is safe and the most effective method of long-term preservation, especially if the cultures cannot be freeze-dried. Cryoprotectants are used as carriers of the fungal mycelium on the agar medium disks (Hwang 1968). There are two types of cryoprotectants—those such as glycerol and dimethyl sulfoxide (DMSO) that act as penetrating agents, which protect fungal cells intracellularly and extracellularly by passing through cell membranes, and nonpenetrating agents such as glucose, sucrose, lactose, dextran, mannitol, sorbitol, polyvinyl-pyrrolidone, and hydroxyethyl starch, which exert their protective effects external to the cell membrane (Nakasone et al. 2004). Several other cryoprotectants have also been used as carriers for preserving mycelium. These include polypropylene and perlite, which was developed originally for some basidiomycetes (Homolka et al. 2001). Although it has many advantages, liquid nitrogen is time consuming and a costly technique due to the relatively high cost of the apparatus used, the refrigeration units, liquid nitrogen storage vessels (dewers), and the liquid nitrogen itself, which must be topped up at regular intervals. This implies that there must be regular and reliable deliveries of liquid nitrogen.
For fungal preservation in liquid nitrogen, several 4 mm diameter plugs cut from vigorously growing cultures are placed in sterilized 2 ml cryovial screw-cap tubes filled with 0.5–1.0 ml sterile 10% glycerol solution. Alternatively, the fungal colony on the surface of the plates is flooded with 10% glycerol or 5% DMSO and gently scraped with a fine pipette to obtain a spore suspension, which is carefully transferred with a pipette in aliquots of 0.5 ml into the cryovials. Tubes are either placed directly into a liquid-nitrogen tank (−170°C) after labeling and placing them into special racks or they can be put into a programmed freezing chamber subject to a freezing scheme. In the second choice, racked vials are kept in 4°C for about 10 min, then they are allowed to cool from 4°C to −40°C at a rate of 1°C/minute and from −40°C to −90°C at 10°C/minute and subsequently transferred to liquid nitrogen vapor (−150°C to −180°C). Polypropylene straws are an efficient alternative to cryovials. They are cheap and require less space in the liquid nitrogen containers. The short straw segments (4 cm long) are heat sealed. To increase survival rate, the straws should be cooled; this can be achieved by placing them into the top portion of a −70°C freezer, and leaving them for at least 4 h before they are transferred to the liquid nitrogen.
Liquid nitrogen preservation has been used for the storage of many phytopathogenic fungi and is the preferred method of storage used by some of the large culture collections. Urediniospores of Puccinia graminis f. sp. tritici were preserved in liquid nitrogen for the first time by Loegering and Harmon (1961).
Microbank preservation
The use of marketable cryogenic tubes (Microbank vials) stored at −70°C for the storage and preservation of fungi was found to be especially appropriate for long-term storage (Chandler 1994; Baker and Jeffries 2006). They can be used for various types of pathogenic fungi. Microbank provides vials containing a cryopreservative and porous beads to serve as supporting carriers, since microorganisms readily adhere to the bead surface. Vials containing about 25 coloured beads each are inoculated with the fungus under aseptic conditions. For extended storage, vials are kept at −70°C or in liquid nitrogen. Cultures are retrieved by removing a single bead from the vial, which is then placed on a suitable culture medium for growth. The advantage of using the Microbank system over other cryogenic systems (Pasarell and McGinnis 1992; Espinel-Ingroff et al. 2004) is their commercial availability. The time-consuming procedure of preparing other preservative devices such as drinking straws (Stalpers et al. 1987) or containers of cryogenic fluid is avoided. Microbank vials are stored at room temperature prior to use.
Preservation by lyophilization
Lyophilization (freeze drying) is a convenient technique favoured by many large culture collections (Onions 1983; Gallo et al. 2008). This process allows storage for 20–40 years; however, there are some restrictions such as the recovery time for resuscitation of the preserved isolate in order to obtain optimum viability without sub-lethal damage; this requires carefully designed and controlled protocols. In addition, the equipment is expensive and must be maintained. With this technique, it is often only the fungal conidia that survive (Smith 1993; Borman et al. 2006). Nevertheless, storage by lyophilization is one of the most suitable methods for maintaining viable and stable fungal cultures for long periods, and is a preferred method for storage of bacteria. Lyophilization of an isolate can be obtained by freezing and drying a suspension of the fungal pathogen in its nutritive medium. The actual freeze drying operation is done using a freeze dryer working in conjunction with a vacuum apparatus. Ampoules with lyophilized fungi are sealed with heat, to prevent damage of lyophilized material as a result of contact with air.
Fungal cultures that are 7–10 days old can be selected for lyophilization according to the procedure outlined by Smith and Onions (1994). About 1.5–2 ml of skimmed milk is added to a slanted culture and the surface of the agar gently scraped with a Pasteur pipette to obtain a spore suspension. The spore suspension is added to each lyophilization tube and the latter loosely plugged with cotton. The contents of each tube are frozen for 10 min by immersing the tubes in a dry ice and ethylene glycol bath. The open end of the glass tube is lubricated with castor oil while subjected to a vacuum for about 30 min until a suitable system pressure has been reached. Tubes are then sealed under vacuum using a gas-oxygen torch. Lyophilized cultures can be stored at 4°C in sealed plastic containers until used.
The use of freeze drying as a preservation method for fungi was first reported by Raper and Alexander (1945) and an improved method was described by Heckly (1978) and Jong et al. (1984). Many species of phytopathogenic fungi have been successfully maintained by freeze drying (Bunse and Steigleder 1991; Larena et al. 2003; Milošević et al. 2007).
Outlook
Efficient mycological research requires a reliable source of cultures (i.e., well-defined and taxonomically determined isolates) maintained in a safe and stable storage environment. Routine subculturing is not a very practical method for storing large numbers of fungal cultures. It is time-consuming, prone to contamination and does not prevent genetic and physiological changes that take place as a consequence of long-term and frequent subculturing.
Long-term preservation of fungi is an essential scientific requirement for the research carried out in most modern plant pathology laboratories, particularly those using molecular facilities. It is important that viability and stability of cultures are ensured during the preservation period. Isolates of many fungi can be preserved cheaply in sterile distilled water at room temperature, but the stability of the fungal cells is not ensured. Cultures of fungi can also be cheaply and conveniently preserved in soil or on oil- or water-covered slants in small laboratories. Cryopreservation in liquid nitrogen is probably the safest way for preservation, but it is costly and time consuming. Storage in liquid nitrogen vapour is less expensive and more convenient for long-term preservation of fungal cultures. Lyophilization provides a mechanism for stabilizing the cultures for long periods of time but the time involved in carrying out this procedure is lengthy and the latter also requires expensive equipment. Because of cost constraints and space requirement each plant pathology laboratory or culture collection must select the most reliable and suitable storage method for its own use.
However, the choice of a preservation method depends largely on the service required. For instance, a teaching collection does not demand a guarantee of the stability and longevity that is absolutely essential for a national type culture depository. Nevertheless, a taxonomic collection requires the conservation of morphological features (e.g., conidia form of the fungus) whereas an industrial collection needs to retain a stable metabolic state. Also, the capability of fungal pathogens to sporulate or to infect a host may be lost after repeated transfers. Such changes in the fungus will not, of course, affect the extraction of DNA for molecular study. There is no ideal method, so several different methods may have to be used, depending on both the particular species of fungus and the available resources.
Keeping a culture collection is a long-term commitment, often fraught with difficulties over the maintenance of equipment, provision of sufficient staff resources and finance. Cultures can unexpectedly loose viability or become contaminated with other mould fungi or bacteria. Multiple tubes/vials must be kept of each fungal isolate. Even successful maintenace of viability does not always guarantee retention of morphology, the ability to sporulate or to retain various characteristics such as pathogenicity. Some genera such as Alternaria, Bipolaris, Curvularia, Drechslera, Stemphylium, etc. will often only produce misshapen conidia after long-term storage, while these genera and others such as Phoma, Phomopsis, etc. may loose the ability to sporulate altogether.
It must be reiterated that dried specimens kept in herbaria also have their place alongside collections of living cultures. Perhaps efforts should be made to ensure that representative cultures of fungi are dried down and deposited with the plant/fungus specimen. This will help to provide a good indication of what the fungus originally looked like. In the future such dried cultures may provide a rich source of DNA for study, especially when free of any host plant material. For some fungi, morphology and size of microscopic structures in culture is never the same as on host material. Mycologists and plant pathologists must be encouraged to deposit voucher material of all fungi that they work on, preferably depositing both cultures and herbarium specimens. Where feasible, GenBank sequences must be supported by specimens and/or cultures.
References
Agrios GN (2004) Plant pathology, 5th edn. Elsevier Academic, Burlington
Atkinson RG (1954) Quantitative studies on the survival of fungi in five-year-old dried soil cultures. Can J Bot 32:673–678
Baker M, Jeffries P (2006) Use of commercially available cryogenic vials for long-term preservation of dermatophyte fungi. J Clin Microbiol 44:617–618
Bakerspiegel A (1953) Soil as a storage medium for fungi. Mycologia 45:596–604
Balajee SA, Gribskov J, Brandt M, Ito J, Fothergill A, Marr KA (2005) Mistaken Identity: neosartorya pseudofischeri and its anamorph masquerading as Aspergillus fumigatus. J Clin Microbiol 43:5996–5999
Barrett RW, Johnson GB, Ogata WN (1965) Wild-type and mutant stocks of Aspergillus nidulans. Genetics 52:233–246
Baskarathevan J, Jaspers MV, Jones EE, Ridgway HJ (2009) Evaluation of different storage methods for rapid and cost-effective preservation of Botryosphaeria species. New Zeal Plant Prot 62:234–237
Boesewinkel HJ (1976) Storage of fungal cultures in water. Trans Brit Mycol Soc 66:183–185
Borba CM, Rodrigues KF (2000) Viability and sporulating capability of Coelomycetes preserved under a range of different storage regimes. Rev Iberoam Micol 17:142–145
Borman AM, Szekely A, Campbell CK, Johnson EM (2006) Evaluation of the viability of pathogenic filamentous fungi after prolonged storage in sterile water and review of recent published studies on storage methods. Mycopathol 161:361–368
Buell CB, Weston WH (1947) Application of the mineral oil conservation method for maintaining collections of fungus cultures. Am J Bot 34:555–561
Bueno CJ, Ambrósio MM, Souza NL (2006) Storage of soilborne phytopathogenic fungi. Summa Phytopathol 32:42–50
Bunny FJ (1981) Variation in the pathogenicity of Gaeumannomyces graminis after storage. Austral Plant Path 10:22
Bunse T, Steigleder GK (1991) The preservation of fungal cultures by liophilization. Mycoses 34:173–176
Burdsall HH Jr, Dorworth EB (1994) Preserving cultures of wood-decaying Basidiomycotina using sterile distilled water in cryovials. Mycologia 86:275–280
Cahill DM, Rookes JE, Wilson BA, Gibson L, McDougall KL (2008) Phytophthora cinnamomi and Australia’s biodiversity: impacts, predictions and progress towards control. Austral J Bot 56:279–310
Cai L, Hyde KD, Taylor PWJ, Weir BS, Waller J, Abang MM, Zhang JZ, Yang YL, Phoulivong S, Liu ZY, Prihastuti H, Shivas RG, McKenzie EHC, Johnston PR (2009) A polyphasic approach for studying Colletotrichum. Fungal Divers 39:183–204
Cannon PF, Buddie AG, Bridge PD (2008) The typification of Colletotrichum gloeosporioides. Mycotaxon 104:189–204
Carmichael JW (1962) Viability of mold cultures stored at −20ºC. Mycologia 54:432–436
Castellani A (1939) The viability of some pathogenic fungi in sterile distilled water. J Trop Med Hyg 42:225–226
Chandler D (1994) Cryopreservation of fungal spores using porous beads. Mycol Res 98:525–526
Crous PW (2009) Taxonomy and phylogeny of the genus Mycosphaerella and its anamorphs. Fungal Divers 38:1–24
Crous PW, Braun U (2003) Mycosphaerella and its anamorphs: 1. Names published in Cercospora and Passalora. CBS Biodivers Series 1
Crous PW, Kang JC, Braun U (2001) A phylogenetic redefinition of anamorph genera in Mycosphaerella based on ITS rDNA sequence and morphology. Mycologia 93:1081–1101
Crous PW, Wingfield MJ, Mansilla JP, Alfenas AC, Groenewald JZ (2006) Phylogenetic reassessment of Mycosphaerella spp. and their anamorphs occurring on Eucalyptus. II. Stud Mycol 55:99–131
Crous PW, Braun U, Groenewald JZ (2007) Mycosphaerella is polyphyletic. Stud Mycol 58:1–32
de Vries RP, Frisvad JC, van de Vondervoort PJI, Burgers K, Kuijpers AFA, Samson RA, Visser J (2005) Aspergillus vadensis, a new species of the group of black Aspergilli. Anton Leeuwen 87:195–203
Deighton FC (1974) Studies on Cercospora and allied genera. V. Mycovellosiella Rangel, and a new species of Ramulariopsis. Mycol Pap 137:1–75
Deighton FC (1976) Studies on Cercospora and allied genera. VI. Pseudocercospora Speg., Pantospora Cif. and Cercoseptoria Petr. Mycol Pap 140:1–168
Delatour C (1991) A very simple method for long-term storage of fungal cultures. Euro J Forest Patholo 21:444–445
Diogo HC, Sarpieri A, Pires MC (2005) Fungi preservation in distilled water. An Bras Dermatol 80:591–594
Elliott TJ (1976) Alternative ampoule for storing fungal cultures in liquid nitrogen. Trans Br Mycol Soc 67:545–546
Elliott ML (2005) Survival, growth and pathogenicity of Gaeumannomyces graminis var. graminis with different methods of long-term storage. Mycologia 97:901–907
Ellis JJ (1979) Preserving fungus strains in sterile water. Mycologia 71:1072–1075
Espinel-Ingroff A, Montero D, Mazuelos EM (2004) Long-term preservation of fungal isolates in commercially prepared cryogenic Microbank vials. J Clin Microbiol 42:1257–1259
Frank J, Crous PW, Groenewald JZ, Oertel B, Hyde KD, Phengsintham P, Schroers HJ (2010) Microcyclospora and Microcyclosporella: novel genera accommodating epiphytic fungi causing sooty blotch on apple. Persoonia 24:93–105
Frisvad JC, Smedsgaard J, Samson RA, Larsen TO, Thrane U (2007) Fumonisin B2 Production by Aspergillus niger. J Agric Food Chem 55:9727–9732
Gallo MBC, Guimaraes DO, Luciano da SM, Pupo MT (2008) Natural products from endophytic fungi. In: Saikia R, Bezbaruah RL, Bora TC (eds) Microbial Biotechnology. New India Publishing Agency, pp 138–168
Geiser DM (2004) Practical molecular taxonomy of fungi. In: Lange L, Tkacz J (eds) Advances in fungal biotechnology for industry, medicine and agriculture. Kluwer Academic, New York
Geiser DM, Klich MA, Frisvad JC, Peterson SW, Varga J, Samson RA (2007) The current status of species recognition and identification in Aspergillus. Stud Mycol 59:1–10
Grivell R, Jackson F (1969) Microbial culture preservation with silica gel. J Gen Microbiol 58:423–425
Hartung de Capriles C, Mata S, Middelveen M (1989) Preservation of fungi in water (Castellani): 20 years. Mycopathol 106:73–79
Hawksworth DL (1974) Mycologist’s handbook. Commonwealth Mycological Institute, Kew
Heckly RJ (1978) Preservation of microorganisms. Adv Appl Microbial 24:l–53
Heinonen TH, Holopainen T (1991) Maintenance of ectomycorrhizal fungi. In: Norris JR, Read DJ, Varma AK (eds) Methods in microbiology 23. Academic, London, pp 413–422
Homolka L, Lisá L, Eichlerová I, Nerud F (2001) Cryopreservation of some basidiomycete strains using perlite. J Microbiol Methods 47:307–313
Hong SB, Go SJ, Shin HD, Frisvad JC, Samson RA (2005) Polyphasic taxonomy of Aspergillus fumigatus and related species. Mycologia 97:1316–1329
Hornby D, Bateman GL, Gutteridge RJ, Lucas P, Osbourn AE, Ward E, Yarham DJ (1998) Take-all disease of cereals. In: Hornby D (ed) A regional perspective. CAB International, Wallingford, p 384
Hwang SW (1968) Investigation of ultra-low temperature for fungal cultures. I. An evaluation of liquid nitrogen storage for preservation of selected fungal cultures. Mycologia 60:613–621
Hyde KD, Cai L, Cannon PF, Crouch JA, Crous PW, Damm U, Goodwin PH, Chen H, Johnston PR, Jones EBG (2009) Colletotrichum: names in current use. Fungal Divers 39:147–183
Ito T, Yokoyama T (1983) Preservation of basidiomycete cultures by freezing. IFO Res Commum 11:60–70
Jong SC, Levy A, Stevenson RE (1984) Life expectancy of freeze-dried fungus cultures stored at 4 ºC. In: Kocur M, Dasilva E (eds) Proceedings of the fourth international conference on culture collections. World Federation of Culture Collections, London, pp 125–136
Kang S, Blair JE, Geiser DM, Khang CH, Park SY, Gahegan M, O’Donnell K, Luster DG, Kim SH, Ivors KL, Lee YH, Lee YW, Grünwald NJ, Martin FM, Coffey MD, Veeraraghavan N, Makalowska I (2006) Plant pathogen culture collections: It takes a village to preserve these resources vital to the advancement of agricultural security and plant pathology. Phytopathol 96:920–925
Kvas M, Marasas WFO, Wingfield BD, Wingfield MJ, Steenkamp ET (2009) Diversity and evolution of Fusarium species in the Gibberella fujikuroi complex. Fungal Divers 34:1–21
Larena I, Melgarejo P, de Cal A (2003) Drying of conidia of Penicillium oxalicum, a biological control agent against fusarium wilt of tomato. J Pytopathol 151:600–606
Larsen TO, Smedsgaard J, Nielsen KF, Hansen ME, Frisvad JC (2005) Phenotypic taxonomy and metabolite profiling in microbial drug discovery. Nat Prod Rep 22:672–695
Legard DE, Chandler CK (2000) Cryopreservation of strawberry pathogen in mechanical ultra-low temperature freezer. Hort Science 15:1357
Loegering WQ, Harmon DL (1961) A long term experiment for preservation of urediniospores of Puccinia graminis tritici in liquid nitrogen. Plant Dis Rep 45:284–285
Manoharachary C, Sridhar K, Singh R, Adholeya A, Suryanarayanan TS, Rawat S, Johri BN (2005) Fungal biodiversity: distribution, conservation and prospecting of fungi from India. Current Sci 89:58–71
Mayner Y, Bennetjt W, Tallant J (1971) Instability of an aflatoxin-producing strain of Aspergillus parasiticus. Mycologia 63:644–648
McGinnis MR, Padhye AA, Ajello L (1974) Storage of stock cultures of filamentous fungi, yeasts, and some aerobic actinomycetes in sterile distilled water. Appl Microbiol 28:218–222
McNeill J, Barrie FF, Burdet HM, Demoulin V, Hawksworth DL, Marhold K, Nicolson DH, Prado J, Silva PC, Skog JE, Wiersema J, Turland NJ (2006) International code of botanical nomenclature (Vienna Code) adopted by the Seventeenth International Botanical Congress, Vienna, Austria, July 2005. Regnum Veg 146:568
Milošević MB, Medić-Pap SS, Ignjatov MV, Petrović DN (2007) Lyophilization as a method for pathogens long term preservation. Proc Nat Sci, Matica Srpska Novi Sad 113:203–210
Mizrahi A, Miller G (1968) Long-term preservation of a non-sporulating strain of Claviceps paspali. Appl Microbiol 16:1100–1101
Murakami H, Yoshida K, Yoshida K, Noro F (1979) Tables of mycological characters of the representative strains of the black aspergilli. Taxonomic studies on Japanese industrial strains of the Aspergillus (Part 30). J Soc Brew Jpn 74:466–470
Nakasone KK, Peterson SW, Jong SC (2004) Preservation and distribution of fungal cultures. In: Foster MS, Bills GF, Mueller GM (eds) Biodiversity of fungi: Inventory and monitoring methods. Elsevier Academic, USA, pp 37–47
Nelson EE, Fay HA (1985) Maintaining cultures of wood rotting fungi. U.S. Department of Agriculture, Forest Service, Pacific Northwest. Forest and Range Experiment Station, Portland, Oregon. Res Note PNW 428:1–3
Nielsen KF, Smedsgaard J, Larsen TO, Lund F, Thrane U, Frisvad JC (2004) Chemical identification of fungi: metabolite profiling and metabolomics. In: Arora DK (ed) Fungal biotechnology in agricultural, food, and environmental application. Marcel Dekker, New York, pp 19–35
O’Donnell K, Ward TJ, Geiser DM, Kistler HC, Aoki T (2004) Genealogical concordance between the mating type locus and seven other nuclear genes supports formal recognition of nine phylogenetically distinct species within the Fusarium graminearum clade. Fungal Genet Biol 41:600–623
Okane I, Lumyong S, Nakagiri A, Ito T (2003) Extensive host range of an endophytic fungus, Guignardia endophyllicola (anamorph: Phyllosticta capitalensis). Mycoscience 44:353–363
Onions AHS (1983) Preservation of fungi. In: Smith JE, Berry DR, Kristiansen B (eds) The Filamentous Fungi, vol. 4: Fungal Technology. Edward Arnold, Great Britain, pp 373–390
Parinao V, Patrikeevv V, Lysenkos V (1972) Investigation of the survival and physiological activity of some yeast strains after long storage in silica gel. Mikrobiologiya 41:164
Pasarell L, McGinnis MR (1992) Viability of fungal cultures maintained at −70ºC. J Clin Microbiol 30:1000–1004
Perkins DD (1962) Preservation of Neurospora stock cultures with anhydrous silica gel. Can J Microbiol 8:591–594
Perrin PW (1979) Long-term storage of cultures of wood-inhabiting fungi under mineral oil. Mycologia 71:867–869
Phoulivong S, Cai L, Chen H, McKenzie EHC, Abd-Elsalam K, Chukeatirote E, Hyde KD (2010) Colletotrichum gloeosporioides is not a common pathogen on tropical fruits. Fungal Divers. doi:10.1007/s13225-010-0046-0
Pointing SB, Hyde KD (eds) (2001) Bio-exploitation of filamentous fungi. Fungal diversity research series 6. Fungal Diversity, Hong Kong
Pringle A, Baker DM, Platt JL, Wares JP, Latge JP, Taylor JW (2005) Cryptic speciation in the cosmopolitan and clonal human pathogenic fungus Aspergillus fumigatus. Evolution 59:113–126
Puhallaj E (1968) Compatibility reactions on solid medium and interstrain inhibition in Ustilago maydis. Genetics 60:461–474
Puhallaj E, Anagnostaksi SL (1971) Genetics and nutritional requirements of Endothia parasitica. Phytopathol 61:169–173
Pumpianskaya LV (1964) Storage of microorganisms under mineral oil. Mikrobiologiya 33:1065–1070
Raper KB, Alexander DF (1945) Preservation of moulds by the lyophil process. Mycologia 37:499–525
Reinecke P, Fokkema NJ (1979) Pseudocercosporella herpotrichoides: storage and mass production of conidia. Trans Brit mycol Soc 72:329–330
Reinharddt J (1966) Silica gel as a preserving agent for the cellular slime mould Acrasisrosea. J Protozool 13:225–226
Rodrigues EG, Lírio VS, Lacaz CS (1992) Preservation of fungi and actinomycetes of medical importance in distilled water. Rev Inst Med Trop 34:159–165
Rogers WG (1972) Studies of the taxonomy and pathology of Verticillium species. Ph.D. Thesis, University of Wales
Roy AJ (1968) Some fungi from Almora. Indian Phytopathol 20:340–348
Ryan MJ, Jeffries P, Bridge PD, Smith D (2001) Developing cryopreservation protocols to secure fungal gene function. Cryo Lett 22:115–124
Salustiano ME, Pozza EA, Ferraz Filho AC, Castro HA (2008) Viability of Puccinia pisidii urediniospores stored in different environments. Trop Plant Pathol 33:313–316
Schipper MAA, Holtman JB (1976) Viability of lyophilized fungal cultures. Antonie Leeuwenhoek J Microbiol 42:325–328
Shearer BL, Zeyen RJ, Ooka JJ (1974) Storage and behaviour in soil of Septoria species isolated from cereals. Phytopathol 64:163–167
Sherf AF (1943) A method for maintaining Phytomonas sepedonica in culture for long periods without transfer. Phytopathol 33:330–332
Simpfendorfer S, Harden TJ, Murray GM (1996) Viability and pathogenicity of Phytophthora clandestina after storage in water and liquid nitrogen. Australasian Plant Pathol 25:234–239
Singleton LL, Mihail JD, Rush CM (eds) (1992) Methods for research on soilborne phytopathogenic fungi. American Phytopathological Society, St. Paul
Smith D (1993) Long-term preservation of test strains (fungus). Int Biodet Biodeg 31:227–230
Smith D, Onions AHS (1994) The preservation and maintenance of living fungi, 2nd edn. CAB International, Wallingford, p 122
Sneh B, Burpee L, Ogoshi A (1991) Identification of Rhizoctonia species. American Phytopathological Society, St. Paul
Stalpers JA, De Hoog A, Vlug IJ (1987) Improvement of the straw technique for the preservation of fungi in liquid nitrogen. Mycologia 79:82–89
Steinkraus DC, Boys GO, Slaymaker PH (1993) Culture, storage, and incubation period of Neozygites fresenii (Entomophthorales: Neozygitaceae) a pathogen of the cotton aphid. Southw Entomol 18:197–202
Stephenson SL (2010) The Kingdom fungi: The biology of mushrooms, molds and lichens. Timber, Portland
Trollope DR (1975) The preservation of bacteria and fungi on anhydrous silica gel: an assessment of survival over four years. J Appl Bacteriol 38:115–120
van der Aa HA (1973) Studies in Phyllosticta I. Stud Mycol 5:1–110
van der Aa HA, Vanev S (2002) A revision of the species described in Phyllosticta. Centraalbureau voor Schimmelcultures, Utrecht
van Niekerk JM, Crous PW, Groenewald JZ, Fourie PH, Halleen F (2004) DNA phylogeny, morphology and pathogenicity of Botryosphaeria species on grapevines. Mycologia 96:781–798
Windels CE, Burnes PM, Kommedahl T (1988) Five-year preservation of Fusarium species on silica gel and soil. Phytopathol 78:107–109
Windels CE, Burnes PM, Kommedahll T (1993) Fusarium species stored on silica gel and soil for ten years. Mycologia 85:21–23
Wulanderi NF, To-Anun C, Hyde KD, Duong LM, de Gruyter J, Meffert JP, Crous PW (2009) Phyllosticta citriasiana sp. nov., the cause of Citrus tan spot of Citrus maxima in Asia. Fungal Divers 34:23–39
Acknowledgments
Financial support for the development of this paper was provided by the Dean of Scientific Research, King Saud University, Saudi Arabia. YuanYing Su is thanked for technical assistance.
Author information
Authors and Affiliations
Corresponding author
Rights and permissions
About this article
Cite this article
Abd-Elsalam, K.A., Yassin, M.A., Moslem, M.A. et al. Culture collections, the new herbaria for fungal pathogens. Fungal Diversity 45, 21–32 (2010). https://doi.org/10.1007/s13225-010-0063-z
Received:
Accepted:
Published:
Issue Date:
DOI: https://doi.org/10.1007/s13225-010-0063-z